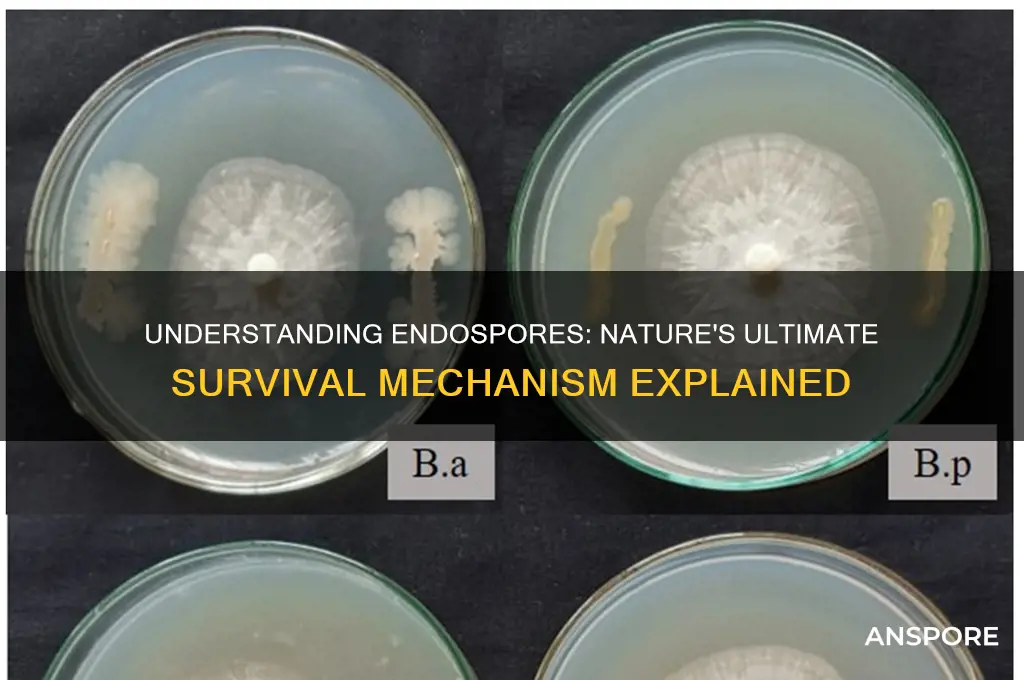
what are endo spores

Endospores are highly resistant, dormant structures produced by certain bacteria, primarily from the genus *Bacillus* and *Clostridium*, as a survival mechanism in harsh environmental conditions. Unlike vegetative cells, endospores are not a reproductive structure but rather a protective form that allows the bacterium to withstand extreme temperatures, radiation, desiccation, and chemical exposure. They are formed through a complex process called sporulation, where the bacterial cell undergoes a series of morphological and biochemical changes to create a durable, metabolically inactive spore. Once favorable conditions return, the endospore can germinate, reverting to its vegetative state and resuming growth, making them a remarkable example of bacterial resilience and adaptability.
| Characteristics | Values |
|---|---|
| Definition | Endospores are highly resistant, dormant structures produced by certain bacteria, primarily within the Firmicutes phylum, in response to adverse environmental conditions. |
| Formation | Formed through a process called sporulation, involving asymmetric cell division and encapsulation of DNA within a protective layer. |
| Location | Typically found within the bacterial cell, often appearing as a distinct, refractile body under a microscope. |
| Resistance | Highly resistant to extreme conditions, including heat, radiation, desiccation, chemicals, and enzymes. |
| Structure | Consists of a core containing DNA, surrounded by a cortex (peptidoglycan layer), spore coat (protein layer), and sometimes an exosporium (outer covering). |
| Metabolism | Metabolically inactive in the dormant state, with minimal or no detectable metabolic activity. |
| Germination | Can revert to vegetative state (germination) under favorable conditions, resuming metabolic activity and growth. |
| Longevity | Can remain viable for extended periods, ranging from years to millennia, depending on environmental conditions. |
| Examples | Produced by bacteria such as Bacillus (e.g., B. anthracis) and Clostridium (e.g., C. botulinum). |
| Ecological Role | Serve as a survival mechanism, allowing bacteria to persist in harsh environments until conditions improve. |
| Detection | Detected through methods like heat treatment, staining (e.g., Schaeffer-Fulton stain), and microscopy. |
| Applications | Used in biotechnology, food preservation, and as biological indicators for sterilization processes. |
What You'll Learn
- Endospore Formation: Process of sporulation in bacteria, creating resistant, dormant cells under stress
- Endospore Structure: Composed of core, cortex, spore coat, and exosporium layers for protection
- Endospore Function: Ensures bacterial survival in extreme conditions like heat, radiation, and chemicals
- Endospore Germination: Process of returning to vegetative state when favorable conditions return
- Endospore Examples: Found in genera like *Bacillus* and *Clostridium*, common in soil and water

Endospore Formation: Process of sporulation in bacteria, creating resistant, dormant cells under stress
Under stress, certain bacteria initiate a remarkable survival strategy: endospore formation. This process, known as sporulation, transforms a vulnerable vegetative cell into a highly resistant, dormant endospore capable of withstanding extreme conditions like heat, radiation, and desiccation. Unlike typical bacterial reproduction, sporulation is not about multiplication but about preservation, ensuring the bacterium’s genetic continuity in hostile environments. This mechanism is most famously observed in genera like *Bacillus* and *Clostridium*, where endospores can remain viable for centuries, only reverting to active cells when conditions improve.
The sporulation process begins with an asymmetric cell division, where the bacterium partitions into a larger mother cell and a smaller forespore. This division is not merely physical but also biochemical, as the forespore accumulates specialized proteins and a thick, protective coat. The mother cell then engulfs the forespore, providing additional layers of protection, including a cortex rich in peptidoglycan and a proteinaceous coat. Finally, the mother cell lyses, releasing the mature endospore into the environment. This intricate process is regulated by a cascade of genetic signals, ensuring precision and efficiency in response to stress.
From a practical standpoint, understanding endospore formation is critical in fields like food safety and medicine. For instance, *Clostridium botulinum* endospores can survive standard cooking temperatures, emphasizing the need for high-pressure processing (e.g., 70–120°C for 10–30 minutes) to ensure food safety. Similarly, in healthcare, endospores of *Bacillus anthracis* pose a bioterrorism threat due to their resilience. Decontamination protocols often involve autoclaving at 121°C for 15–30 minutes, a measure derived from the known resistance of endospores. These examples highlight the importance of targeting the sporulation process to mitigate risks effectively.
Comparatively, endospore formation stands apart from other bacterial survival strategies, such as biofilm formation or cyst development in parasites. While biofilms provide collective protection through extracellular matrices, endospores offer individual, long-term survival. Unlike cysts, which are less resistant and more specific to certain organisms, endospores are a bacterial-exclusive adaptation, showcasing the evolutionary ingenuity of prokaryotes. This distinction underscores why endospores are a focal point in both research and applied sciences.
In conclusion, endospore formation is a fascinating and functionally critical process that exemplifies bacterial resilience. By creating dormant, stress-resistant cells, bacteria like *Bacillus* and *Clostridium* ensure their survival in environments that would otherwise be lethal. Whether in the context of food preservation, medical sterilization, or environmental microbiology, understanding sporulation is key to addressing challenges posed by these resilient organisms. Practical applications, from autoclaving protocols to food processing techniques, are directly informed by this unique bacterial strategy, making it a cornerstone of modern scientific and industrial practices.
Fungal Spores: Fruiting Body Formation Before Germination Explained
You may want to see also

Endospore Structure: Composed of core, cortex, spore coat, and exosporium layers for protection
Endospores are nature's ultimate survival capsules, engineered by certain bacteria to endure extreme conditions. Their structure is a marvel of biological fortification, consisting of four distinct layers: the core, cortex, spore coat, and exosporium. Each layer serves a specific protective function, ensuring the genetic material within remains intact even under harsh environments such as heat, radiation, or desiccation. Understanding this architecture reveals how these microscopic structures can persist for centuries, waiting for optimal conditions to reactivate.
The core is the heart of the endospore, housing the bacterium's DNA, ribosomes, and essential enzymes in a dehydrated state. This dehydration reduces metabolic activity to near-zero levels, preserving the cell's viability. Surrounding the core is the cortex, a peptidoglycan-rich layer that provides structural integrity and acts as a buffer against mechanical stress. The cortex also plays a role in spore germination, as its degradation signals the return to vegetative growth. These inner layers are critical for survival but are not sufficient alone—they require additional shielding.
The spore coat is where the endospore's resilience truly shines. Composed of keratin-like proteins, this layer is highly impermeable, repelling solvents, enzymes, and other damaging agents. Its toughness is comparable to materials like silk or chitin, making it a formidable barrier. In some species, the spore coat also contains calcium dipicolinate, a compound that stabilizes the core's DNA under high temperatures. This layer is so effective that it can withstand autoclaving, a process that kills most microorganisms.
Outermost is the exosporium, a thin, hair-like layer that acts as the endospore's first line of defense. It is often covered in glycoproteins and lipids, which help the spore adhere to surfaces and evade detection by the immune system. While not present in all endospores, the exosporium enhances survival in specific environments, such as soil or water. Its presence underscores the adaptability of these structures, tailoring their defenses to their ecological niche.
Practical applications of endospore structure are vast. For instance, in the food industry, understanding the spore coat's resistance to heat informs sterilization techniques like retorting, which uses high temperatures to destroy contaminants. Conversely, in biotechnology, the durability of endospores is leveraged for long-term storage of bacterial strains. For hobbyists or researchers culturing bacteria, knowing that the cortex swells during germination can help optimize growth conditions by providing adequate moisture and nutrients. This layered defense system is not just a biological curiosity—it’s a blueprint for resilience, offering lessons in protection and preservation across disciplines.
Mastering Spore Sax Acquisition: A Comprehensive Guide for Enthusiasts
You may want to see also

Endospore Function: Ensures bacterial survival in extreme conditions like heat, radiation, and chemicals
Bacteria, despite their microscopic size, have evolved remarkable strategies to endure harsh environments that would be lethal to most life forms. One such strategy is the formation of endospores, a dormant, highly resistant structure that enables certain bacterial species to survive extreme conditions. These conditions include, but are not limited to, high temperatures, intense radiation, and exposure to toxic chemicals. The endospore’s primary function is to ensure the bacterium’s survival during unfavorable periods, allowing it to persist until more hospitable conditions return. This resilience is achieved through a combination of structural and biochemical adaptations that make endospores one of the most durable life forms on Earth.
Consider the process of autoclaving, a common sterilization method in laboratories and medical settings, which involves exposing materials to saturated steam at 121°C (250°F) for 15–20 minutes. While this process effectively kills most vegetative bacteria, endospores of species like *Clostridium botulinum* and *Bacillus anthracis* can withstand such extreme heat. This survival is attributed to the endospore’s multilayered structure, which includes a thick proteinaceous coat, a cortex rich in peptidoglycan, and a core containing highly dehydrated DNA and protective proteins. These layers act as a shield, preventing damage from heat, desiccation, and chemicals. For instance, endospores can survive exposure to hydrogen peroxide, ethanol, and even some disinfectants, making them a challenge in sterilization protocols.
From a practical standpoint, understanding endospore function is crucial in industries such as food preservation and healthcare. In food processing, endospores of *Bacillus* and *Clostridium* species are a significant concern, as they can survive conventional cooking temperatures and cause food spoilage or illness if activated. To combat this, food manufacturers employ techniques like thermal processing at temperatures exceeding 100°C (212°F) for extended periods or use of high-pressure processing (HPP) to inactivate endospores. Similarly, in healthcare, endospores pose a risk in surgical instruments and medical devices, necessitating the use of specialized sterilization methods like steam sterilization with prolonged cycles or chemical sterilants such as glutaraldehyde.
A comparative analysis highlights the endospore’s superiority in survival mechanisms when contrasted with other bacterial forms. While vegetative cells rely on rapid reproduction and metabolic activity, endospores adopt a "wait-and-see" approach, remaining dormant for years or even centuries. This strategy is particularly advantageous in environments prone to sudden, drastic changes, such as soil exposed to seasonal variations or space environments with extreme radiation. For example, endospores of *Bacillus subtilis* have been found in ancient sediments, viable after thousands of years, and have even survived exposure to outer space, demonstrating their unparalleled ability to endure extreme conditions.
In conclusion, the endospore’s function as a survival mechanism is a testament to bacterial adaptability. Its ability to withstand heat, radiation, and chemicals makes it a critical subject of study in microbiology, with practical implications for sterilization, food safety, and even astrobiology. By understanding the structural and biochemical basis of endospore resistance, scientists and industries can develop more effective strategies to control or harness these resilient bacterial forms. Whether in a hospital, a food processing plant, or a spacecraft, the endospore’s role in bacterial survival underscores its significance in both natural and human-engineered environments.
Shiitake Mushroom Growth Timeline: From Spores to Harvest
You may want to see also

Endospore Germination: Process of returning to vegetative state when favorable conditions return
Endospores, the resilient survival structures of certain bacteria, can endure extreme conditions for centuries. But their true marvel lies in their ability to awaken. Endospore germination is the intricate process by which these dormant forms revert to active, metabolizing cells when the environment becomes hospitable again. This transformation is not merely a reactivation but a carefully orchestrated sequence of events, ensuring the bacterium's survival and proliferation.
Imagine a seed sprouting after a long winter. Similarly, endospore germination begins with a signal—a change in temperature, pH, or nutrient availability. This triggers the uptake of water, a critical step known as activation. The endospore's impermeable coat, which has shielded it from harsh conditions, now allows water to penetrate, rehydrating the core. This initial hydration is followed by the release of enzymes that degrade the protective layers, exposing the dormant cell within. For instance, in *Bacillus subtilis*, the enzyme germinant receptor triggers the breakdown of the cortex, a process that can be inhibited by low calcium concentrations, highlighting the sensitivity of this stage.
The next phase, outgrowth, is where the real transformation occurs. The bacterial cell within the endospore resumes metabolic activity, synthesizing new cell wall components and restoring its DNA to a functional state. This stage is energy-intensive, requiring nutrients like glucose and amino acids. Studies show that *Clostridium botulinum* endospores, for example, germinate efficiently in the presence of specific amino acids like L-alanine, which act as potent germinants. The timing of this process is crucial; premature germination in an unfavorable environment could be fatal, while delayed germination might miss the window of opportunity for growth.
Practical applications of understanding endospore germination are vast. In food preservation, knowing the conditions that trigger germination helps in designing more effective sterilization methods. For instance, commercial canning processes often involve heating food to 121°C for 15 minutes to ensure the destruction of endospores, particularly those of *Clostridium botulinum*, which can cause botulism. Conversely, in biotechnology, controlled germination is used to produce enzymes and other biomolecules from bacteria like *Bacillus*. Researchers are also exploring endospore germination as a model for studying cellular resurrection, with potential implications for astrobiology and the search for life in extreme environments.
In summary, endospore germination is a finely tuned process that bridges dormancy and life, driven by environmental cues and metabolic revival. Its study not only deepens our understanding of bacterial survival strategies but also offers practical solutions in industries ranging from food safety to biotechnology. Whether you're a microbiologist, a food scientist, or simply curious about life's resilience, the mechanisms of endospore germination provide a fascinating glimpse into the adaptability of microorganisms.
Bacillus Subtilis Spores: Unveiling Their Formation and Functionality
You may want to see also

Endospore Examples: Found in genera like *Bacillus* and *Clostridium*, common in soil and water
Endospores, highly resistant structures produced by certain bacteria, are nature's answer to extreme survival. Among the most well-known endospore-forming genera are *Bacillus* and *Clostridium*, which thrive in environments as diverse as soil and water. These microorganisms encapsulate their genetic material within a protective shell, enabling them to withstand conditions that would destroy most life forms, including heat, radiation, and desiccation. This resilience makes them both fascinating subjects of study and potential hazards in various contexts.
Consider *Bacillus anthracis*, the causative agent of anthrax, which forms endospores that can persist in soil for decades. These spores are so durable that they have been weaponized in bioterrorism incidents, highlighting the dual-edged nature of their survival capabilities. In contrast, *Bacillus subtilis*, a non-pathogenic species, is widely used in biotechnology for its ability to produce enzymes and antibiotics under harsh conditions. Understanding these examples underscores the importance of distinguishing between beneficial and harmful endospore-forming bacteria in practical applications.
Clostridium species, another prominent endospore-forming genus, are often found in anaerobic environments like soil and the gastrointestinal tract. Clostridium botulinum, for instance, produces botulinum toxin, one of the most potent toxins known, from its endospores under favorable conditions. Despite this, Clostridium species also have industrial uses, such as Clostridium acetobutylicum, which is employed in biofuel production due to its ability to ferment sugars into solvents. These contrasting roles illustrate the complexity of managing endospore-forming bacteria in both health and industry.
To mitigate risks associated with pathogenic endospores, practical measures include proper sterilization techniques, such as autoclaving at 121°C for 15–20 minutes, which effectively destroys these resilient structures. In agricultural settings, crop rotation and soil testing can help manage *Bacillus* and *Clostridium* populations. For individuals handling materials potentially contaminated with endospores, wearing protective gear and adhering to biosafety protocols is essential. By recognizing the specific habitats and behaviors of these genera, we can better navigate their presence in soil and water, turning knowledge into actionable safeguards.
Mastering Mushroom Cultivation: A Simple Guide to Making Spore Slurry
You may want to see also
Frequently asked questions
Endospores are highly resistant, dormant structures produced by certain bacteria, primarily from the genus *Bacillus* and *Clostridium*, to survive harsh environmental conditions such as heat, radiation, and chemicals.
Endospores form through a process called sporulation, where a bacterium divides asymmetrically, creating a smaller cell (forespore) within the larger cell. The forespore is then encased in protective layers, including a cortex, spore coat, and sometimes an exosporium.
No, endo spores are extremely resilient and require extreme conditions, such as high temperatures (e.g., autoclaving at 121°C for 15–30 minutes) or strong chemicals, to be destroyed.
Endospores are important because they allow certain bacteria to survive in unfavorable environments for long periods, posing challenges in food preservation, sterilization, and medical settings. Understanding them helps in developing effective disinfection methods.

